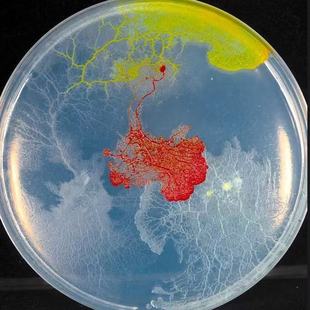
黏菌宠物菌种菌核史莱姆小之微多头绒泡菌学生迷宫生物实验小宠物

黏菌菌核

黏菌菌种菌核粘菌史莱小之微曳尾刚丝多头绒泡菌宠物小型好养活体


黏菌宠物饲养套装菌种菌核粘菌宠物学生小宠物曳尾菌多头绒菌培养


黏菌宠物菌核菌种培养粘菌饲养套装史莱姆学生实验染色迷宫曳尾菌


黏菌宠物菌种菌核培养粘菌迷宫曳尾菌学生家养好养史莱姆小宠物活


黏菌菌种菌核粘菌史莱小之微曳尾刚丝多头绒泡菌宠物小型好养活体


黏菌菌种菌核饲养套装迷宫染色粘菌宠物儿童学生宿舍好养活小宠物


黏菌宠物菌种粘菌迷宫饲养套装多头绒泡菌核学生儿童生物实验培养


菌王争霸赛黏菌菌种菌核宠物小好养活体变形多头绒泡菌染色粘菌


黏菌宠物菌种菌核饲养套装粘菌染色迷宫培养小孩儿童生日礼物宠物


黏菌菌种菌核粘菌宠物迷宫染色剂饲养套装钢丝多头绒泡菌培养皿


黏菌宠物菌核菌种培养粘菌多头绒泡菌史莱姆学生儿童实验饲养套装


黏菌宠物菌种菌核饲养套装粘菌染色迷宫培养小孩儿童生日礼物宠物


黏菌菌种菌核粘菌宠物迷宫染色剂饲养套装钢丝多头绒泡菌培养皿


多头绒泡菌黏菌种菌核玻璃星球宠物小好养活体小之微染色粘菌


菌核粘菌迷宫饲养套装宠物菌种小型绒泡菌刚丝多头绒泡菌好养活体


黏菌菌种菌核粘菌史莱姆小之微曳尾刚丝多头绒泡菌宠物小型好养活


黏菌宠物多头刚丝绒泡菌粘菌活体菌核菌种好养史莱姆超小型微生物


黏菌菌种菌核粘菌史莱姆小之微曳尾刚丝多头绒泡菌宠物小型好养活


黏菌宠物饲养套装菌核培养皿曳尾菌学生科学实验好养史莱姆小礼物


黏菌菌种菌核粘菌史莱小之微曳尾刚丝多头绒泡菌宠物小型好养活体


菌王争霸赛黏菌多头绒泡菌菌种菌核宠物小型好养活体粘菌


黏菌宠物菌种菌核培养粘菌迷宫曳尾菌学生家养好养史莱姆小宠物活


黏菌宠物菌种菌核培养粘菌迷宫曳尾菌学生家养好养史莱姆小宠物活


黏菌宠物菌种饲养套装菌核培养皿在学校可以养学生实验兴趣培养


多头刚丝绒泡菌黏菌种菌核玻璃星球宠物小好养变形小之微染色


黏菌多头绒泡菌粘菌宠物黏菌地图黏菌菌核变形菌宠物


黏菌宠物饲养套装菌种菌核粘菌宠物学生小宠物曳尾菌多头绒菌培养

黏菌宠物菌种菌核史莱姆小之微多头绒泡菌学生迷宫生物实验小宠物


黏菌宠物菌种菌核多头绒泡菌培养学生儿童实验饲养套装曳尾菌治愈


黏菌宠物菌种菌核饲养套装粘菌染色迷宫培养小孩儿童生日礼物宠物


黏菌宠物菌种菌核培养粘菌史莱姆套装小之微曳尾菌多头绒泡菌染色


黏菌宠物饲养套装菌种菌核粘菌宠物学生小宠物曳尾菌多头绒菌培养


曳尾菌黏菌宠物菌种菌核培养多头绒泡菌小学生儿童实验史莱姆好养


黏菌宠物高活性饲养套装菌核培养皿好养曳尾菌学生科学实验小礼物


黏菌宠物高活性饲养套装菌核培养皿好养曳尾菌学生科学实验小礼物


黏菌菌种菌核粘菌史莱小之微曳尾刚丝多头绒泡菌宠物小型好养活体


黏菌宠物饲养套装菌种菌核粘菌宠物学生小宠物曳尾菌多头绒菌培养


黏菌宠物菌核菌种迷宫曳尾菌史莱姆饲养套装学生版家养小宠物染色


黏菌宠物菌核菌种培养粘菌史莱姆饲养套装曳尾菌学生宠物好养冷门


黏菌宠物菌核菌种培养粘菌多头绒泡菌史莱姆学生儿童实验饲养套装




